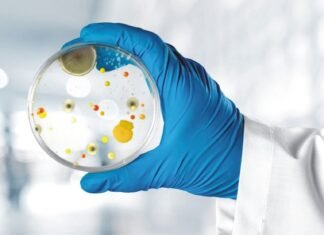
Strategies of Mold Control in Monsoon

Indian university issues advisory against pest infesting maize crops
Punjab Agricultural University has issued an advisory to manage the fall armyworm, an invasive insect-pest that has been infesting maize crops in Punjab since...
Fluctuation in global prices for Vitamin B3 Niacinamide & D3 500
This week's Feed Additive Focus, brought to you by Glowlit, takes a look at the latest price changes in VITAMIN B3 NIACINAMIDE and VITAMIN D3 500
Spot buyers...
Mr. T. Natesan Promoted as Managing Director of Virbac India
Mr. T. Natesan is now promoted as a Managing Director of Virbac India.Mr. Satish Pasrija the leader who has vision, courage, humility and a...
Feed Additives Price Update
This week's Feed Additive Focus, brought to you by Glowlit, takes a look at the latest price changes in Vitamin E50, Vitamin A1000, Vitamin D3 500, Canthaxanthin 10% & Vitamin...
AB Vista appoints new Managing Director
AB Vista has appointed Juan Ignacio Fernandez as its new managing director, replacing Richard Cooper who has retired after 16 years in the role....
DSM ignites new strategic initiative to transform global animal nutrition and...
Leading animal nutrition and health company making animal production sustainability possible
Mumbai: 28th August 2020:As the world’s population grows, demand for animal protein will continue...
Effect of Early Post Hatch Feeding on the Development and Functioning...
Introduction
Paying special attention to young animal nutrition is important to achieve the full production capacity of birds and to ensure sustainable business for the...
Wageningen based collaboration to make sustainable animal feed
To replace cereals in animal feed with less sticky co-products from circular agriculture, there is an urgent need to find out how animal feed...
Strategies of Mold Control in Monsoon
Abstract
Mold growth in feeds occurs when desirable temperature, oxygen, unbound water, and nutrients are available. Mitigation of these four factors prevent mold growth. Management...
USDA Report on Zambia’s corn export for 2020-21
Corn is the most important crop in Zambia. It is widely grown by smallholder farmers and is the national staple food. In the 2020/21...
Indian Sub-continent – A key market for Evonik
Amino acid demand is increasing in the Indian sub-continent observes German chemical company. Think Grain Think Feed interviewed Mr. Vinod Paremal who recently took...
Short term outlook of sluggish Maize market
The pandemic resulted in weak demand for maize against its abundant supplies. Prices for rabi crops in major producing states were reported to fluctuate...
Oilmeal imports in India increase substantially
Import of oilmeals, used as animal feed, rose 70% in 2019-20 because of higher demand, stagnant local production and lower duty of shipments from...
Superdosing of Phytase – A concept to increase animal performance
Introduction
Phytic acid (Inositol Hexaphosphate- IP6) is a low solubility compound present in broiler feed. It has an anti-nutritive factor as Phosphorus is present in...
BENISON Media in collaboration with Glowlit launches new section on Feed...
Benison Media has announced collaboration with Glowlit, a global market intelligence platform creating value for stakeholders across the animal feed supply chain.
Benison Media and...
Insect meal insertion may positively impact broiler growth
The polish research finds that small amount addition of T. molitor and Z. morio full-fat meals to the diet of broiler chickens can improve...
China seeks ‘COVID-19 Free’ guarantee from Argentine grains exporters
Argentine grains exporters told Chinese importers that they were asking for "inappropriate" guarantees that crops being shipped from the South American country were free...
Role of Fibre in Layer Diet
In the recent past Fibre was not so much important particularly in commercial layer diet, though it was a part of feed formulation depending...
Novus International files Methionine Antidumping Petitions with US Government
SAINT CHARLES, MISSOURI (29 July 2020) – Novus International, Inc. today filed antidumping petitions with the U.S. Department of Commerce and International Trade Commission....
SYMAGA has completed the installation of a new drilling centre
SYMAGA has completed the installation of a new drilling centre, boosting our steel profile automatic processes range. This line brings a new era in...